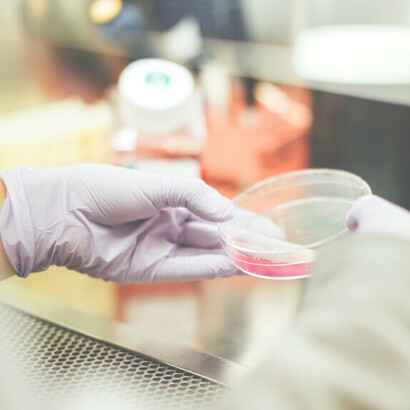
Fármacos anticancerígenos: hay muchos tipos de inmunoterapia que se usan para tratar y posiblemente curar algunos tipos de cáncer.

Por primera vez en la historia, un nuevo medicamento pudo eliminar por completo el cáncer en cada paciente en un ensayo clínico sin causar efectos secundarios adversos.1, 2 Hizo que algunos afirmaran que finalmente podría haber una cura para el cáncer.3 En realidad, el cáncer no es solo una enfermedad, son muchas enfermedades. Además, los pacientes fueron seleccionados porque tenían una forma rara de cáncer de recto (deficiencia en la reparación de errores de emparejamiento de ADN) que se observa en solo entre el 5 y el 10 por ciento de los pacientes con cáncer de recto. Los pacientes con tales tumores tienden a responder menos a los tratamientos de quimioterapia y radiación, lo que aumenta la necesidad de la extirpación quirúrgica de sus tumores. Por lo general, los pacientes con este tipo de tumores rectales pueden esperar someterse a quimioterapia y radioterapia antes de la extirpación quirúrgica del cáncer. Pueden sufrir disfunción intestinal y vesical, incontinencia, infertilidad, disfunción sexual y más. Los pacientes de este estudio hasta ahora han evitado por completo estos procedimientos y sus efectos secundarios asociados. Sin embargo, las mutaciones del ADN que causan la deficiencia en la reparación de errores de emparejamiento pueden hacer que las células cancerosas sean más vulnerables a la respuesta inmunitaria, especialmente cuando se mejora con un inhibidor de puntos de control. Por lo tanto, el fármaco experimental Dostarlimab (vendido bajo el nombre de Jemperli) podría ser una cura para una forma especial de cáncer de recto, pero ha tenido menos éxito en la curación de otros tipos de cáncer.4, 5 Aun así, este nuevo fármaco es importante en el campo de la inmunoterapia, en la que se utiliza el propio sistema inmunitario para curar diferentes tipos de cáncer.6-9
Un sistema inmunológico saludable puede prevenir el cáncer, especialmente cuando está respaldado por un microbioma intestinal saludable que proviene del consumo de fibra dietética y de evitar la carne.10, 11 Las formas en que un sistema inmunitario saludable respalda la salud humana se describieron en un artículo anterior de esta revista.12 Las células inmunitarias producidas en la glándula del timo (células T) pueden reconocer las células cancerosas como no propias y desencadenar una respuesta adecuada que las elimina antes de que puedan crecer y hacer metástasis. El sistema inmunitario examina el cuerpo, encuentra células cancerosas y las ataca para destruirlas. Esto se llama inmunovigilancia. Los tumores son editados por el sistema inmunitario, pero algunas variantes resistentes lo evitan debido a una inmunovigilancia insuficiente. Entonces, los investigadores buscaron formas de mejorar el sistema inmunológico. Uno de los primeros éxitos de la inmunoterapia fue en el tratamiento del melanoma cutáneo metastásico con una proteína llamada interleucina aprobada por la FDA en 1998 para el tratamiento del melanoma en etapa IV con IL-2 para estimular la proliferación de glóbulos blancos. Sin embargo, solo se observó una tasa de respuesta general del 19%, con una tasa de respuesta completa de solo el 4%, lo que limita el uso de esta estrategia. Sin embargo, algunas células cancerosas desarrollan la capacidad de expresar una proteína específica en su superficie que hace que las células inmunitarias mueran. Esta proteína se llama muerte programada 1 (en inglés, programmed cell death 1, PD-1). La investigación sobre inmunoterapia contra el cáncer tiene como objetivo superar la capacidad de las células cancerosas para resistir las respuestas inmunitarias y estimular los propios mecanismos del cuerpo que le permiten seguir siendo eficaz contra el cáncer.13, 14
Hay un receptor PD-1 en la superficie de las células T activadas.15 Es un inhibidor del punto de control inmunitario que media la inmunosupresión. Es una parte importante de nuestra protección natural contra el cáncer a través de un ciclo de inmunidad contra el este. El ciclo permite que el sistema inmunitario tenga una respuesta anticancerígena y elimine las células cancerosas. Primero, las células dendríticas capturan células tumorales que tienen antígenos de superficie celular mutados. En segundo lugar, las células dendríticas preparan las células T con el antígeno tumoral, activando así las células T citotóxicas. En tercer lugar, las células T activadas viajan al tumor y se infiltran en su entorno. Cuarto, las células T activadas reconocen y se unen a las células cancerosas. En quinto lugar, las células T efectoras unidas liberan citotoxinas que inducen la muerte celular programada (apoptosis) en las células cancerosas a las que se dirigen. Finalmente, las células cancerosas que mueren liberan más antígenos asociados con el tumor que propagan aún más el ciclo de inmunidad y matan más células cancerosas. Sin embargo, esta respuesta debe regularse adecuadamente para mantener el equilibrio entre el reconocimiento y la destrucción adecuados de los tumores y la sobreestimulación inapropiada de las respuestas inmunitarias, que pueden provocar daños en las células y tejidos normales y sanos. La vía de señalización de PD-1 (o PD-L1) es una parte esencial de esta regulación.
Hay dos proteínas que pueden unirse al receptor PD-1. Cuando una proteína se une a otra, se llama ligando. Entonces, los bioquímicos las llaman PD-L1 y PD-L2.15 Se expresan ampliamente en la superficie de las células dendríticas y macrófagas en el sistema inmunitario. PD-L1 y PD-L2 son proteínas de control inmunitario que actúan como factores coinhibidores. Pueden detener o limitar el desarrollo de la respuesta de las células T. La interacción entre PD-L1 y PD-L2 con su receptor afín asegura que el sistema inmunitario se active solo en los momentos apropiados. Esto minimiza la probabilidad de inflamación autoinmune crónica. Sin embargo, las células tumorales pueden explotar esta vía de control inmunitario, evadir la detección e inhibir la respuesta inmunitaria. El PD-L1 se sobreexpresa con frecuencia en células tumorales o en células no transformadas en el microambiente tumoral. PD-L1 en las células tumorales puede unirse a los receptores PD-1 en las células T activadas. Esto inhibe las células T citotóxicas. Estas células T desactivadas permanecen inhibidas en el microambiente tumoral.
Quizás el paciente más conocido que fue tratado con éxito mediante el bloqueo de PD-1 es el presidente Jimmy Carter, que tenía melanoma metastásico y recibió pembrolizumab (Keytruda®).16
Hay otros tipos de inmunoterapias que han tenido cierto éxito. Por ejemplo, científicos y médicos han eliminado la leucemia en varios pacientes al convertir sus células T citotóxicas en asesinos específicos de células cancerosas.17 Utilizaron un vector lentiviral para expresar receptores de antígenos quiméricos (en inglés, chimeric antigen receptors, CAR) en las células T citotóxicas de los pacientes. El gen para el CAR fue entregado por un vector de lentivirus, que se creó utilizando la columna vertebral del virus VIH-1 que ya no era patógeno y no podía causar el SIDA. Debido a que el huésped natural del VIH-1 es el linfocito T, el vector del lentivirus se dirigió específicamente a las células cancerosas y se multiplicó en ellas. Los pacientes recibieron entre 15 millones y mil millones de linfocitos T citotóxicos.
Una vez que se identifican los antígenos tumorales, se pueden diseñar inmunoterapias activas y pasivas.18 Las inmunoterapias activas inducen una respuesta inmunitaria dirigida al tumor al vacunar a los pacientes con antígenos tumorales. Las inmunoterapias pasivas pueden usar citocinas como IL-2, anticuerpos monoclonales (monoclonal antibody, mAb) y/o células T adoptivas para estimular el sistema inmunitario. También hay un inhibidor de puntos de control llamado CTLA-4 que evita la activación de las células T. Ipilimumab es un mAb humano que bloquea CTLA-4, por lo que se denomina inhibidor del punto de control inmunitario. La FDA aprobó Ipilimumab en 2011 para el tratamiento de pacientes con melanoma metastásico. El Premio Nobel de Fisiología o Medicina en 2018 fue otorgado a los profesores James Allison y Tasuku Honjo por su investigación sobre CTLA-4 y PD-1, respectivamente.
La inmunoterapia pasiva también puede utilizar la terapia de células T adoptivas (adoptive T cell therapy, ACT), en la que los pacientes son tratados con células T reactivas al tumor que se seleccionan y expanden ex vivo.18 Tanto las células T efectoras como las de memoria pueden inducir una remisión completa en pacientes que no pueden curarse con otras terapias contra el cáncer. Las dos fuentes principales de linfocitos T para ACT son el propio tumor y la sangre periférica del paciente. Cuando un tumor está infiltrado por células T antitumorales, estas células pueden aislarse de la masa tumoral resecada. Por ejemplo, se aislaron linfocitos que se infiltran en el tumor de 93 pacientes con melanoma metastásico que habían fracasado en la quimioterapia y otras inmunoterapias, como los tratamientos con IL-2 y anti-CTLA-4. Las células T aisladas del tumor resecado primero se seleccionaron por su reactividad antitumoral y luego se expandieron. Veinte pacientes (22%) lograron una regresión completa con respuestas completas continuas en 19 de ellos después de tres años.
Además, las células T pueden ser modificadas por CAR.18 A diferencia de los receptores de células T, que son específicos para un complejo entre leucocitos humanos (human leukocyte antigens, HLAs) y péptidos, los CAR pueden reconocer antígenos sin depender de ellos. Esto puede hacer que los CAR sean útiles para pacientes con diferentes haplotipos HLA y aumentar la cantidad de objetivos potenciales, incluidos los carbohidratos y los glicolípidos. Aunque una de las primeras terapias CAR exitosas con remisiones completas se informó en un neuroblastoma sólido, también pueden ser eficaces contra las neoplasias malignas hematológicas. El objetivo CAR más investigado es CD19, que se expresa en las células B normales, así como en la mayoría de las células B en la leucemia y los linfomas. Varios estudios clínicos en pacientes con tumores malignos de células B (como CLL) provocaron respuestas parciales y completas en subgrupos de pacientes. Además, dos niños con leucemia linfoblástica aguda recidivante y refractaria fueron tratados con éxito con CAR dirigidos a CD19. Se informó que un niño tenía una regresión completa en curso, mientras que el otro recayó debido al crecimiento de células blásticas que ya no expresaban CD19. Aun así, los CAR CD19 mataron las células leucémicas agresivas. Por lo tanto, las células T con CAR contra otros objetivos en combinación con CAR CD19 pueden ser útiles en tumores que regulan a la baja el objetivo CAR CD19. Basado en el éxito de las terapias CAR en neoplasias malignas hematológicas, la expansión de esta terapia a tumores sólidos puede ser posible. Sin embargo, será más desafiante debido al microambiente tumoral inmunosupresor que puede hacer que la inmunoterapia basada en células sea ineficaz.18 A pesar de esto, un panel de la FDA recomendó la aprobación de la terapia génica CAR-T (Tisagenlecleucel-T, Kymriah®) el 14 de julio de 2017 para pacientes pediátricos y adultos jóvenes con leucemia linfoblástica aguda (LLA) de células B y fue aprobada en agosto.19 La porción extracelular de la proteína CAR tiene un fragmento de anticuerpo que se dirige a CD19. La porción intracelular contiene señalización de células T y dominios coestimuladores que activan las células T y les permiten persistir, mientras ejercen actividad antitumoral. Una vez que la proteína CAR se une a la diana CD19, los dominios intracelulares promueven la expansión de las células T, al tiempo que desencadenan funciones efectoras posteriores que eliminan las células B objetivo, que son malignas. Por lo tanto, las células sanguíneas se extraen del paciente en un centro médico adecuado y se envían al fabricante (Novartis) para su procesamiento. Luego, se envían de vuelta al centro médico y se administran al paciente.
Por lo tanto, hay muchos tipos de inmunoterapia que se usan para tratar y posiblemente curar algunos tipos de cáncer. También se está investigando mucho para desarrollar vacunas que puedan prevenir el cáncer. La misma tecnología que produjo dos vacunas contra la Covid-19 muy exitosas (BNT162b2 de Pfizer/BioNTech y mRNA-1273 de Moderna/Lonza).
Notas
1 Dockrill, P. (2022). Every single patient in this small experimental drug trial saw their cancer disappear. Science Alert. Junio, 6.
2 Cercek, A. et al. (2022). PD-1 blockade in mismatch repair–deficient, locally advanced rectal cancer. New England Journal of Medicine. Junio, 5.
3 Mukhopadhyay, S. (2022). Cancer cure finally here? New drug Dostarlimab cures all patients in trial ‘first time in history’. Mint Junio, 8.
4 Oaknin, A. et al. (2020). Clinical activity and safety of the anti-Programmed Death 1 monoclonal antibody Dostarlimab for patients with recurrent or advanced mismatch repair–deficient endometrial cancer. JAMA Oncology. Vol. 6, pp. 1766-1772.
5 Andre, T. et al. (2020). Safety and efficacy of anti-PD-1 antibody dostarlimab in patients (pts) with mismatch repair deficient (dMMR) GI cancers. Journal of Clinical Oncology. Vol. 38, no. 4_supl, pp. 218-218. Febrero, 1.
6 Pisibon, C. et al. (2021). Immune checkpoints in cancers: from signaling to the clinic. Cancers. Vol. 13, art. 4573.
7 Pardoll, D. M. (2012). The blockade of immune checkpoints in cancer immunotherapy. Nature Reviews Cancer. Vol. 12, pp. 252-264.
8 Sgambato, A. et al. (2016). Anti PD-1 and PDL-1 immunotherapy in the treatment of advanced non-small cell lung cancer (NSCLC): A review on toxicity profile and its management. Current Drug Safety. Vol. 11, pp. 62-68.
9 Topalian, S. L. et al. (2012). Safety, activity, and immune correlates of anti–PD-1 antibody in cancer. New England Journal of Medicine. Vol. 366, pp. 2443-2454.
10 Smith, R. (2020). Dietary fiber, the gut microbiome and health. There is an undeniable link between the brain, the gut and the immune system. Meer. Abril, 24.
11 Smith, R. (2019). Switching to plant-based diet from animal-based diet. Continuously improving dietary guidelines. Meer. Septiembre, 24.
12 Smith, R. (2021). Respuesta del sistema inmunológico al virus SARS-CoV-2. Meer. Mayo, 17.
13 Sgambato, A. et al. (2016). Anti PD-1 and PDL-1 immunotherapy in the treatment of advanced non-small cell lung cancer (NSCLC): A review on toxicity profile and its management. Current Drug Safety. Vol. 11, pp. 62-68.
14 Pardoll, D. M. (2012). The blockade of immune checkpoints in cancer immunotherapy. Nature Reviews Cancer. Vol. 12, pp. 252-264.
15 Topalian, S. L. et al. (2012). Safety, activity, and immune correlates of anti–PD-1 antibody in cancer. New England Journal of Medicine Vol. 366, pp. 2443-2454.
16 Cancer Research Institute, Jimmy Carter’s cancer immunotherapy story. 2022.
17 Radic, M. (2012). Armed and accurate: engineering cytotoxic T cells for eradication of leukemia. BMC Biotechnology. Vol. 12, pp. 1-4.
18 Wayteck, L. et al. A personalized view on cancer immunotherapy. Cancer Letters Vol. 352, pp. 113-125.
19 U.S. FDA. Tisagenlecleucel, FDA Briefing Document, 2017.
20 Smith, R. (2021). Vacunas basadas en tecnología de ARN moderna. Meer. Enero, 17.